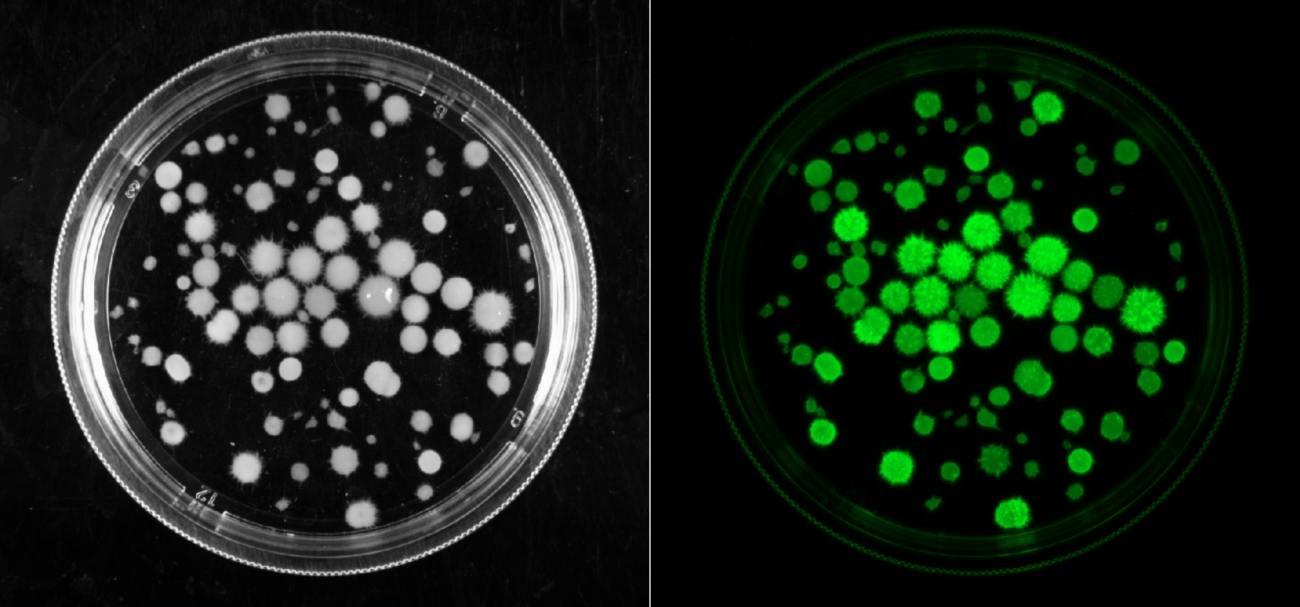
Работа, изменившая представления о природе «живого света». Ученые раскрывают тайны светящихся грибов

Красноярские ученые экспериментально доказали участие системы цитохрома P450 в механизме биолюминесценции высших грибов. Это исследование меняет представления о природе «живого света», и открывает перспективы для применения в биотехнологии, медицине и экологии, в частности, для создания новых биосенсоров. Результаты исследования опубликованы в журнале Asian Journal of Mycology.
Некоторые виды грибов способны светиться в темноте. На сегодняшний день известно более 100 видов светящихся грибов, распространённых по всему миру — от тропиков до умеренных широт. Однако точный биохимический механизм грибного свечения остается не выясненным. Ранее считалось, что свечение грибов обеспечивается только ферментной системой гидроксилаза — люцифераза, однако механизм оказался гораздо сложнее.
Ученые Красноярского научного центра СО РАН представили экспериментальные данные, говорящие об участии системы цитохрома P450 в излучении света высшими грибами. Цитохромы P450 — семейство ферментов, которые играют важную роль в жизнедеятельности живых организмов: участвуют в обмене веществ, преобразовании сложных органических соединений, адаптации к экстремальным условиям среды.
Экспериментальные данные, полученные при работе с мицелием светящихся грибов Neonothopanus nambi, Armillaria borealis, Mycena citricolor и Panellus stipticus, указали на участие системы цитохрома Р450 в светоизлучении высших грибов. Например, специалисты установили, что перекись водорода многократно усиливает грибное свечение, а флуконазол — специфический ингибитор цитохрома P450 — заметно его ослабляет. Проведенные исследования позволили авторам предложить биохимический механизм участия системы цитохрома Р450 в светоизлучении высших грибов: эта система обеспечивает превращение гиспидина — предшественник люциферина — в люциферин и его последующее окисление с участием активных форм кислорода.
«Наше исследование показывает, что биолюминесценция высших грибов — это не результат взаимодействия одного субстрата и одного фермента, а сложный биохимический механизм, в который могут вовлекаться разные ферменты, их системы и разные субстраты. Помимо ферментной системы гидроксилаза - люцифераза в механизме свечения могут участвовать система цитохрома Р450 и оксидазы лигнолитического комплекса грибов, которые способны генерировать активные формы кислорода и с их участием окислять люциферин и иные органические молекулы с излучением света. Это позволяет говорить, что у грибов существует несколько биохимических путей генерации квантов видимого света. В свою очередь, это позволяет по-новому взглянуть на феномен биолюминесценции высших грибов и открывает новые перспективы для её применения в различных научных и прикладных задачах», — рассказывает Никита Ронжин, кандидат биологических наук, старший научный сотрудник Института биофизики СО РАН.
Это открытие дает новое представление о биохимических механизмах грибной биолюминесценции и может найти практическое применение в биотехнологии, медицине и экологии, например, для создания нового класса биосенсоров.